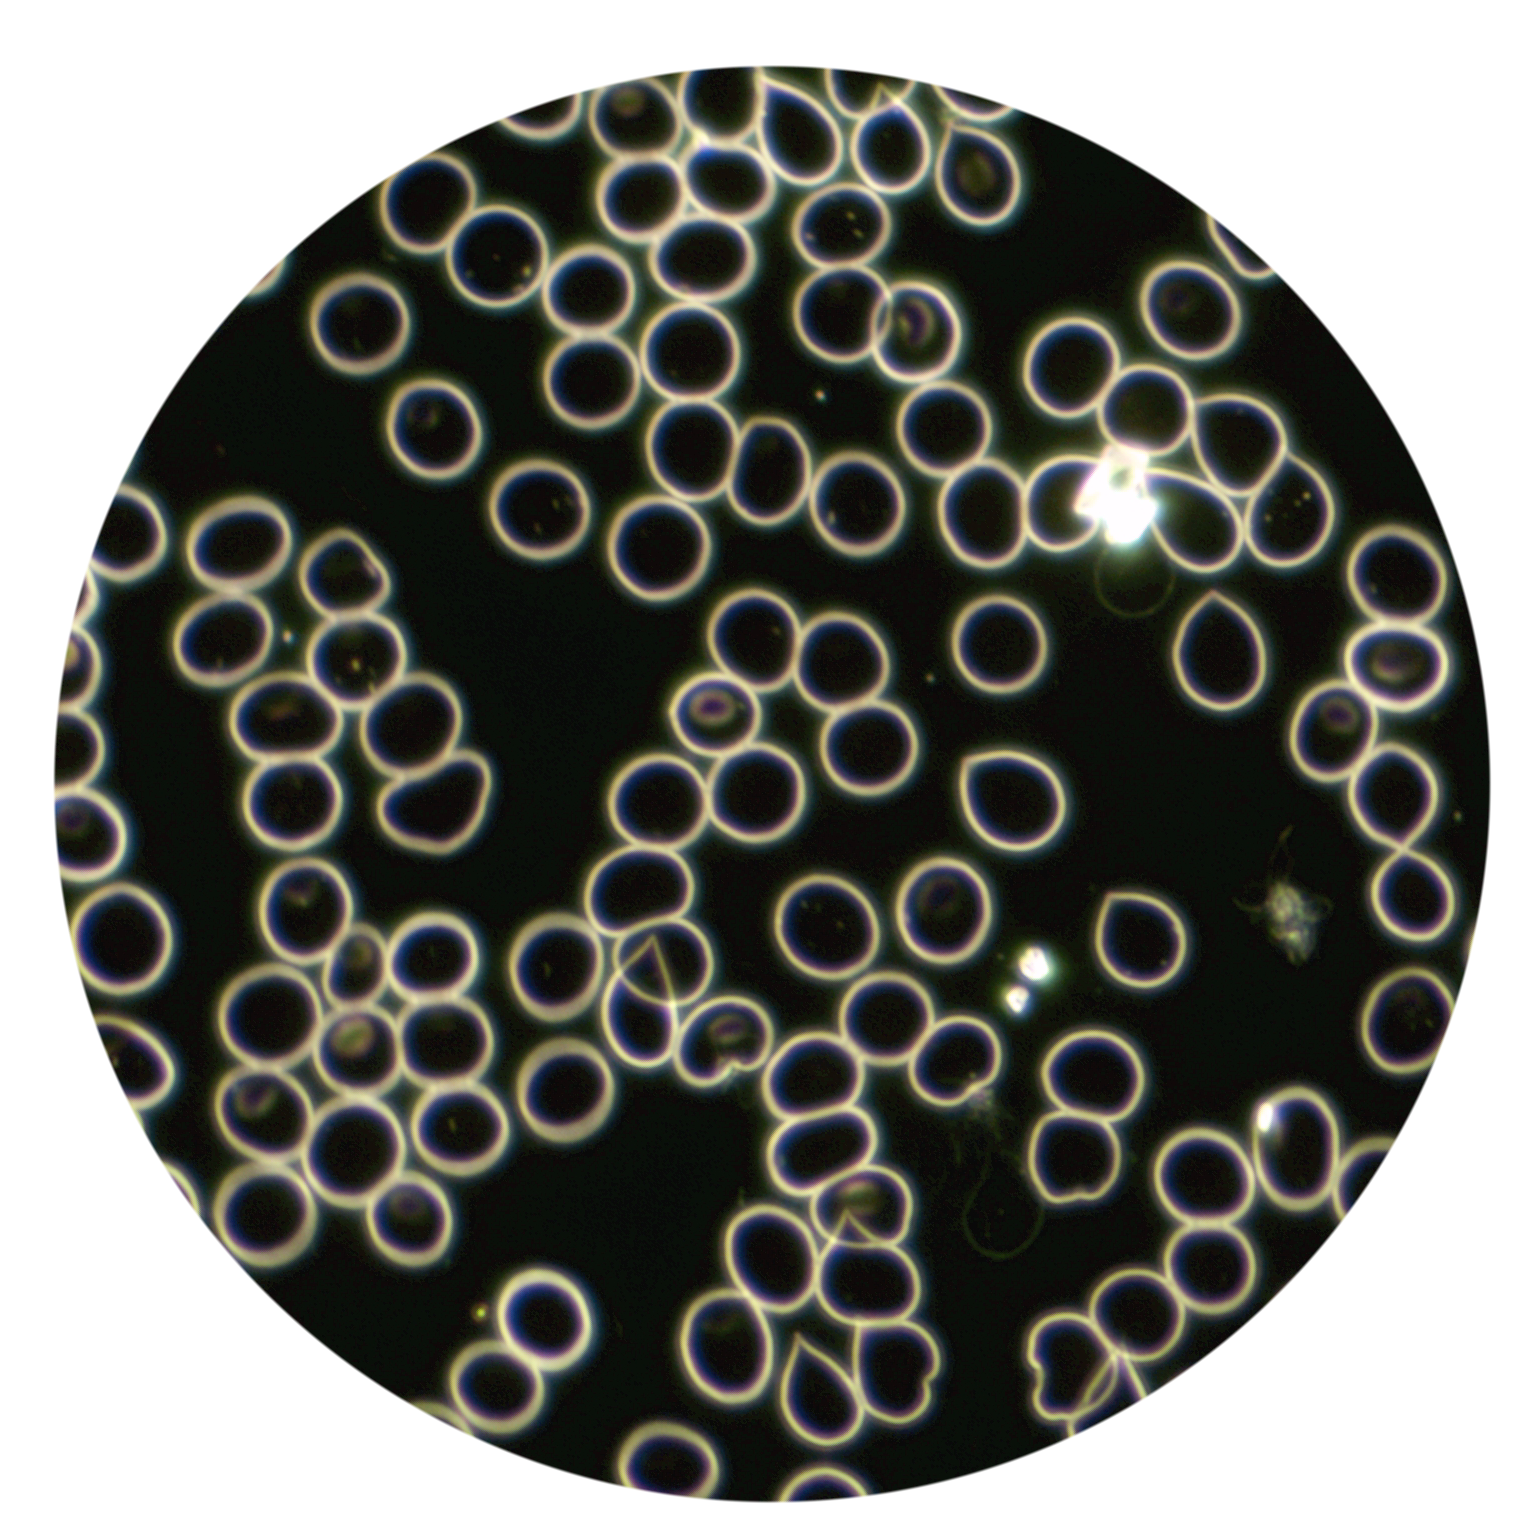

| DFM - Text |
Dunkelfeld-Mikroskopie
Bei dieser Untersuchungsmethode wird ein Tropfen frischen Blutes (Blut-Entnahme vom Finger mit einem kleinen Stich) unter einem Labormikroskop mit bis zu 1000-facher Vergrösserung angeschaut. Diese Methode gehört zu den Naturheilkundlichen Diagnostikverfahren und ist sehr wertvoll, um einen aktuellen Einblick in das Milieu eines Organismus zu bekommen.
Es können Belastungen sichtbar werden, die sonst nicht so leicht herausgefunden werden. Oft ist dies eine Erleichterung für Patienten, die schon seit Jahren in Behandlung sind und ihre Beschwerden aber immer noch haben oder sich einfach noch immer nicht richtig gesund fühlen.
Darum mache ich bei jedem neuen Patienten eine Dunkelfeld-Blutanalyse. Zusammen mit der Iris-Diagnostik, die Hinweise auf die Grundkonstitution eines Menschen liefert, bekomme ich ein gutes Gesamtbild darüber, wie die Therapie anzusetzen ist.
Die Dunkelfeld-Mikroskopie liefert Hinweise auf:
- die Form, Menge und Aktivität der Blutzellen
- Zustand und Inhalt der Blutzellen und des Blutplasmas
- Zustand des Immunsystems
- Lebenskraft des Organismus
- Selbstheilungskraft des Körpers
- Blutgerinnung
- Milieustörungen
- Regulationsblockaden
- Oxidativen Stress
- Säure-Basen-Haushalt
- Wasserhaushalt
- Autoimmunprozesse
- Organbelastungen (Darm, Leber)
- Schwermetallbelastungen
- Belastungen durch Impfungen, Medikamente, Toxine
- Belastung durch zuviele tierische Eiweisse
- Bakterien, Parasiten, Borrelien
- und vieles mehr
Die hier aufgeführten Belastungen können alle möglichen Beschwerden und Krankheiten erzeugen, denen schulmedizinisch mit Medikamenten entgegengewirkt wird, die Ursache jedoch oft weder herausgefunden noch behoben wird.
Jeden Blutstropfen beobachte ich zusammen mit den Klienten, sowie die Tage danach sehr genau. Aus diesem Grund wird für die Dunkelfeld-Mikroskopie CHF 125 verrechnet, zusätzlich zu den Kosten für den Termin.
Bitte möglichst nüchtern zum Termin kommen, also ohne vorher etwas gegessen zu haben, oder nur eine leichte Kost wie Früchte, Salat, Brötchen. Bitte am Termintag, und wenn möglich auch am Abend davor, keine tierischen Produkte essen (Milchprodukte, Käse, Fleisch, Eier), da diese das Bild der Dunkelfeldblut-Untersuchung verfälschen. Dafür viel Wasser oder Kräutertee trinken. Auch auch Kaffee ohne Milch ist ok.
Beim ersten Termin nehmen wir uns 1 1/2 bis 2 Stunden Zeit für:
- Anamnese
- Dunkelfelddiagnostik
- evt. Iris-Diagnostik (je nach Bedarf)
Termine nur montags + dienstags, da ich das Blut den Rest der Woche nachkontrolliere
144 CHF pro 60 Min.
+ 125 CHF für die Dunkelfelddiagnostik
+ Verrechnung von zusätzlicher Zeit für Auswertungen, Rezeptierung, Therapiekonzeptes, sowie Erstellen eines schriftlichen Berichtes zur Iris-Diagnose mit Bildern
Meine Leistungen werden von den Krankenkassen-Zusatzversicherungen übernommen. Einige wenige übernehmen auch die CHF 125 für die Mikroskopie. Der Umfang der Kostenbeteiligung hängt von der Art der Versicherung ab. Kläre den Leistungsumfang mit Deiner Krankenkasse ab. Meine ZSR-Nr. lautet Q195363.
| Unterseite - DFM Grafik (Blut) |
| Unterseite - DFM Grafik (Fredi) |

| clone-Bild DFM-Container 4 |

| Unterseite DFM Bild |


